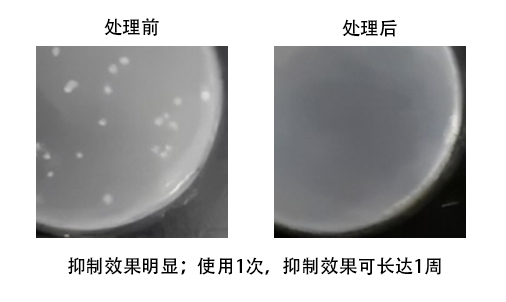

| 货号 | 规格 | 价格 |
| M2308-S | 500mL | ¥160.00 |
| M2308-M | 500mL×2 | ¥280.00 |
| M2308-L | 500mL×6 | ¥820.00 |
产品介绍:
在细胞培养的环境(尤其是细胞房中)及细胞培养箱内,由于温度和湿度非常适宜真菌、细菌、支原体、病毒等微生物的生长,体外细胞培养极易发生污染。此外,细胞培养室各类仪器和环境中的细菌也会造成体外细胞培养发生细菌污染。
Incubator Microbial inhibitor专门用于杀灭细胞培养箱内的真菌、细菌、支原体、病毒等微生物,并可有效预防污染再次出现。
存储条件:
室温,避光存储,2年
产品优势:
安全性:本产品对细胞培养无任何影响,使用时,无需将细胞移出培养箱。
高效广谱:杀菌剂,对细菌、真菌、支原体等杀力强
无腐蚀性:对金属、橡胶制品无腐蚀作用
长效性:使用1次,抑制效果长达1周
案例分析:
注意事项:
为了您的健康,请注意防护,佩戴手套操作;
避免与眼睛和皮肤直接接触,如不慎溅到眼睛或皮肤,请立即用大量清水冲洗;
严禁食用,一旦误服,立即饮用大量清水并尽快就医;
本产品仅供科研使用,严禁用于临床诊断及其它用途。
| 货号 | 产品 | 产品名称 | 规格 | 价格 |
| M2301-S | CellMyco Cleaner | 支原体清除剂 | 500μL | ¥480.00 |
| M2301-M | CellMyco Cleaner | 支原体清除剂 | 500μl×6 | ¥2,680.00 |
| M2301-L | CellMyco Cleaner | 支原体清除剂 | 500μL×12 | ¥4,850.00 |
| M2302-S | M.hyorhinis Cleaner | 猪鼻支原体清除剂 | 500μL | ¥520.00 |
| M2302-M | M.hyorhinis Cleaner | 猪鼻支原体清除剂 | 500μl×6 | ¥2,800.00 |
| M2302-L | M.hyorhinis Cleaner | 猪鼻支原体清除剂 | 500μL×12 | ¥5,200.00 |
| M2303-S | CellMyco Prevention | 支原体预防试剂 | 500μL | ¥260.00 |
| M2303-M | CellMyco Prevention | 支原体预防试剂 | 500μl×6 | ¥980.00 |
| M2303-L | CellMyco Prevention | 支原体预防试剂 | 500μL×12 | ¥1,600.00 |
| M2304-S | MycoFluor Probe | 支原体检测探针 | 10mL | ¥780.00 |
| M2304-M | MycoFluor Probe | 支原体检测探针 | 10mL×2 | ¥1,460.00 |
| M2304-L | MycoFluor Probe | 支原体检测探针 | 10mL×5 | ¥2,800.00 |
| M2305-S | MycoPCR Assay Kit | 支原体PCR检测试剂盒 | 20T | ¥560.00 |
| M2305-M | MycoPCR Assay Kit | 支原体PCR检测试剂盒 | 50T | ¥1,120.00 |
| M2305-L | MycoPCR Assay Kit | 支原体PCR检测试剂盒 | 100T | ¥1,800.00 |
| M2306-S | MDROs Cleaner | 耐药菌清除剂 | 500μL | ¥450.00 |
| M2306-M | MDROs Cleaner | 耐药菌清除剂 | 500μl×6 | ¥2,430.00 |
| M2306-L | MDROs Cleaner | 耐药菌清除剂 | 500μL×12 | ¥4,560.00 |
| M2307-S | Fungal Cleaner | 真菌清除剂 | 500μL | ¥460.00 |
| M2307-M | Fungal Cleaner | 真菌清除剂 | 500μl×6 | ¥2,460.00 |
| M2307-L | Fungal Cleaner | 真菌清除剂 | 500μL×12 | ¥4,580.00 |
| M2308-S | Incubator Microbial inhibitor | 培养箱抑菌喷剂 | 500mL | ¥160.00 |
| M2308-M | Incubator Microbial inhibitor | 培养箱抑菌喷剂 | 500mL×2 | ¥280.00 |
| M2308-L | Incubator Microbial inhibitor | 培养箱抑菌喷剂 | 500mL×6 | ¥820.00 |
| M2309-S | Dish Microbial inhibitor | 水盘抑菌剂 | 100mL | ¥120.00 |
| M2309-M | Dish Microbial inhibitor | 水盘抑菌剂 | 100mL×6 | ¥680.00 |
| M2309-L | Dish Microbial inhibitor | 水盘抑菌剂 | 500mL×12 | ¥1,320.00 |
| M2310-S | Room Microbial inhibitor | 细胞房抑菌喷剂 | 500mL | ¥120.00 |
| M2310-M | Room Microbial inhibitor | 细胞房抑菌喷剂 | 500mL×2 | ¥220.00 |
| M2310-L | Room Microbial inhibitor | 细胞房抑菌喷剂 | 500mL×6 | ¥590.00 |
| M2311-S | Bath Microbial inhibitor | 水浴锅抑菌剂 | 100mL | ¥320.00 |
| M2311-M | Bath Microbial inhibitor | 水浴锅抑菌剂 | 100mL×2 | ¥600.00 |
| M2311-L | Bath Microbial inhibitor | 水浴锅抑菌剂 | 500mL×6 | ¥1,560.00 |
| M2312-S | M.hyorhinis Assay Kit | 猪鼻支原体检测试剂盒 | 20T | ¥560.00 |
| M2312-M | M.hyorhinis Assay Kit | 猪鼻支原体检测试剂盒 | 50T | ¥1,120.00 |
| M2312-L | M.hyorhinis Assay Kit | 猪鼻支原体检测试剂盒 | 100T | ¥1,800.00 |
| M2313-S | CellNano Cleaner | 黑胶虫清除剂 | 500μL | ¥300.00 |
| M2313-M | CellNano Cleaner | 黑胶虫清除剂 | 500μl×6 | ¥1,620.00 |
| M2313-L | CellNano Cleaner | 黑胶虫清除剂 | 500μL×12 | ¥3,000.00 |
| M2314-S | CellNano Prevention | 黑胶虫预防试剂 | 500μL | ¥256.00 |
| M2314-M | CellNano Prevention | 黑胶虫预防试剂 | 500μl×6 | ¥1,400.00 |
| M2314-L | CellNano Prevention | 黑胶虫预防试剂 | 500μL×12 | ¥2,600.00 |